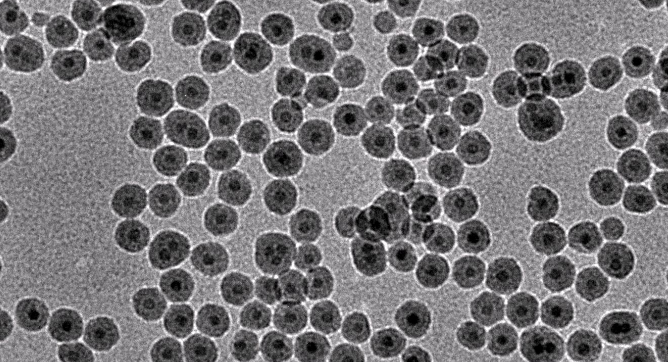
磁性纳米粒

Carboxyl-SiO2@Fe3O4 ,二氧化硅包裹SiO2-Fe3O4超顺磁纳米粒COOH化
发布时间:2023-02-24 分享至:
产品名称:Carboxyl-SiO2@Fe3O4 ,二氧化硅包裹SiO2-Fe3O4超顺磁纳米粒COOH化
中文名称:二氧化硅包裹磁性四氧化三铁纳米粒
英文名称:Carboxyl-SiO2@Fe3O4
外观:固体或粉末
分子量:任意分子量
溶解度:有机溶剂
规格:mg
纯度:95%+
储存:-20℃
用途:科研
Carboxyl-SiO2@Fe3O4 ,二氧化硅包裹SiO2-Fe3O4超顺磁纳米粒COOH化
试剂家主要经营的产品:磷脂、共聚物、PEG衍生物、PEG小分子、点击化学、荧光标记、生物素、光敏剂、金属骨架、量子点、上转换,合成定制产品:脂质体、多肽、荧光探针、大环化合物、交联剂、介孔材料、四氧化三铁、纳米微球、无极发光纳米、一维二维纳米材料;以及实验室技术定制单品:高分子、PROTAC技术、ADC偶联、微环境响应定制、环状/响应性染料、静电纺丝、离子液体、水凝胶、纳米微针、纳米簇等等。温馨提示:试剂家供应产品仅用于科研,不能用于人体。
相关产品:
Mesoporoussilica coating Fe3O4 nanoparticles(100nm)
Fe3O4@SiO2,介孔二氧化硅包裹磁性纳米粒子
FA&RGD标记四氧化三铁(50nm)
FA&RGD-Fe3O4,靶向磁性四氧化三铁纳米粒叶酸化多肽
FA&RGD-Fe3O4,叶酸-多肽-磁性四氧化三铁
RGD标记四氧化三铁(50nm)
RGD-Fe3O4,RGD靶向多肽掺杂四氧化三铁纳米粒
RGD-Fe3O4 ,RGD修饰包载超顺磁性氧化铁纳米粒
RGD-NP-Fe304,RGD标记四氧化三铁
羧基化二氧化硅包四氧化三铁(30nm)5mg/ml
Carboxyl-SiO2-Fe3O4,羧基化二氧化硅包四氧化三铁
PEG-NH2修饰纳米金包四氧化三铁(100nm)5mg/ml
NH2-PEG-Fe3O4,氨基化PEG包裹四氧化三铁纳米颗粒修饰纳米金
NH2-PEG-Fe3O4,PEG化四氧化三铁纳米颗粒(氨基末端)
NH2-PEG-Fe3O4,氨基功能化聚乙二醇包裹的Fe3O4磁性纳米颗粒
Amination SiO2 coating Fe3O4 nanoparticles(30nm)(5mg/ml)
NH2-SiO2-Fe3O4,表面氨基修饰二氧化硅包裹四氧化三铁纳米颗粒
NH2-SiO2-Fe3O4,氨基NH2修饰核壳型纳米粒子